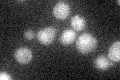
YOR208W
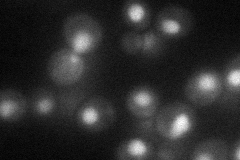
YOR208W
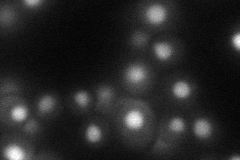
YOR208W

View description
Phosphotyrosine-specific protein phosphatase involved in the inactivation of mitogen-activated protein kinase (MAPK) during osmolarity sensing; dephosporylates Hog1p MAPK and regulates its localization; localized to the nucleus
Localization:
Intensity:
Fold change:
Significance:
-
C’ GFP library in SD
cytosol21.24 -
N' NOP1pr-GFP in SD
nucleus43.9508 -
N' TEF2pr-mCherry in SD
nucleus41.2122 -
N' NATIVEpr-GFP in SD

ambiguous21.7376 -
N' TEF2pr-VC and Cyto-VN in SD

#N/A0 -
C’ GFP library in SD+DTT

cytosol24.041.13No -
C’ GFP library in SD+H2O2

cytosol19.360.91No -
C’ GFP library in Starvation Media

cytosol17.80.83No -
C’ GFP library on the background of Pup2-DaMP

cytosol -
C’ GFP library on the background of CCT mutant

cytosol23.23091.09337No
